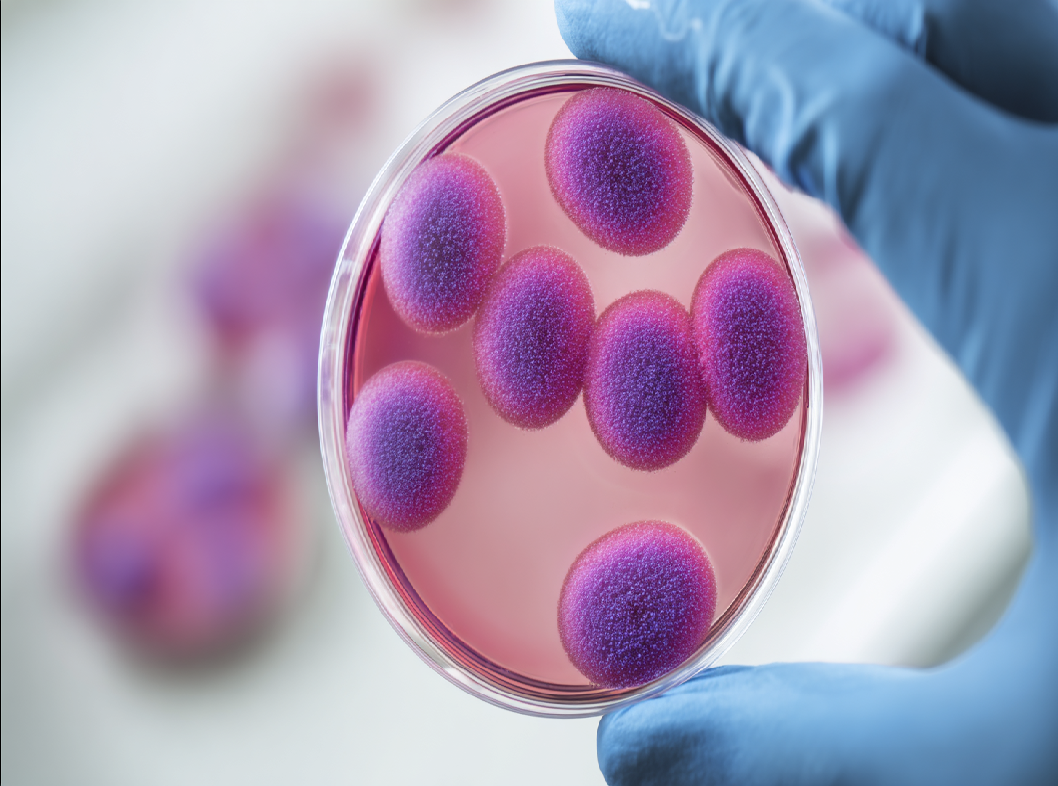
Анализ на стрептококк группы В
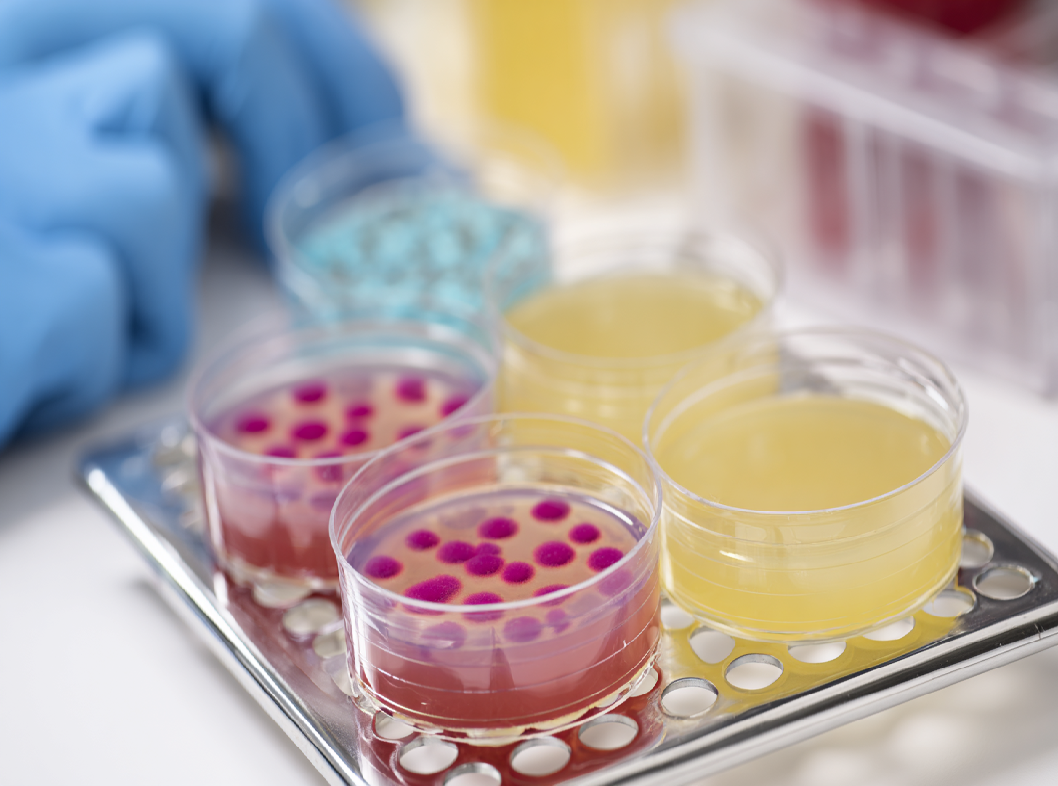
Анализ на стрептококк группы В

Стрептококк группы B (Streptococcus agalactiae), также известный как стрептококк β-гемолитической группы B, является одним из множества видов стрептококков, которые могут населять человеческое тело. Важно различать стрептококка группы B от стрептококка группы A, поскольку они относятся к разным видам и могут вызывать различные инфекции.
Стрептококк группы B обычно обитает в нормальной микрофлоре человека, населяя прежде всего кишечник и половые пути у женщин. У большинства людей стрептококк группы B не вызывает заболеваний и не проявляет себя как патоген. Однако у некоторых людей, особенно у беременных женщин, стрептококк группы B может стать причиной инфекций.
Важное замечание связано с беременностью и новорожденными: стрептококк группы B может передаваться от матери к ребенку во время прохождения родовых путей. Это может вызвать инфекции у новорожденных, такие как пневмония, сепсис и другие.
Для предотвращения передачи стрептококка группы B новорожденному, беременным женщинам обычно проводят тесты на наличие этой бактерии в кишечнике и в области влагалища. Если результат теста положителен, врачи могут принять меры для предотвращения инфекции у новорожденного, например, назначив антибиотики во время родов.
Пути заражения стрептококком группы В
Стрептококк группы B (Streptococcus agalactiae) может передаваться от человека к человеку через различные пути.
Вот некоторые из путей заражения стрептококком группы B:
Вертикальная передача от матери к ребенку во время родов:
Этот путь является одним из наиболее значимых. Если беременная женщина является носителем стрептококка группы B в области влагалища, бактерия может передаваться новорожденному во время прохождения родовых путей. Это может привести к инфекциям у новорожденных, таким как пневмония, сепсис и менингит.
Контакт с зараженными людьми:
Контакт с зараженными людьми, особенно в условиях близкого взаимодействия, может способствовать передаче стрептококка группы B. Это может включать в себя касание зараженных поверхностей или близкий контакт с дыхательными выделениями.
Загрязненные предметы:
Возможна передача бактерии через загрязненные предметы, такие как полотенца, игрушки или другие общие предметы, особенно при условиях недостаточной гигиены.
Контакт с зараженной пищей:
Хотя это менее типичный способ, стрептококк группы B может передаваться через пищу, особенно если продукты были загрязнены бактериями.
Важно отметить, что большинство людей, у которых обнаруживается стрептококк группы B, не развивают инфекции, и бактерия может просто являться частью нормальной микрофлоры. Однако у некоторых людей, особенно у новорожденных и лиц с ослабленной иммунной системой, стрептококк группы B может вызвать серьезные инфекции.
Когда сдавать анализ на стрептококк группы B
Анализ на стрептококк группы B (Streptococcus agalactiae) обычно проводится во время беременности. Этот анализ важен для определения наличия стрептококка группы B в области влагалища у беременных женщин, поскольку бактерия может передаваться от матери к новорожденному во время родов и вызывать различные инфекции.
В большинстве случаев анализ на стрептококк группы B проводится в период беременности между 35 и 37 неделями. Этот временной интервал выбран, чтобы предоставить достаточно времени для принятия мер по предотвращению передачи бактерии новорожденному при родах.
Процедура анализа обычно включает в себя взятие мазка из области влагалища и посев для определения наличия стрептококка группы B. Если результат теста положителен, врачи обычно принимают меры по предотвращению передачи бактерии новорожденному, такие как назначение антибиотиков во время родов.
Важно проконсультироваться с врачом, чтобы уточнить конкретные рекомендации и сроки проведения анализа на стрептококк группы B в вашем случае. Уровень риска заражения и необходимость принятия мер предосторожности могут различаться в зависимости от индивидуальных обстоятельств и медицинской истории.
Результаты анализа на стрептококк группы B
Результаты анализа на стрептококк группы B обычно представляются в виде «положительный» или «отрицательный».
Вот как можно интерпретировать эти результаты:
- Положительный результат:
Если анализ показывает положительный результат, это означает, что стрептококк группы B обнаружен в образце. В этом случае, врач скорее всего примет меры по предотвращению передачи бактерии новорожденному во время родов. - Отрицательный результат:
Отрицательный результат указывает на отсутствие обнаружения стрептококка группы B в образце. В таком случае, дополнительные меры по предотвращению передачи бактерии новорожденному, возможно, не потребуются.
Если результат анализа положителен, врач может назначить антибиотическое лечение во время родов для уменьшения риска передачи стрептококка группы B новорожденному. Это важно, поскольку инфекции, вызванные этим микробом, могут быть серьезными у новорожденных, включая пневмонию, сепсис и менингит.
Если у вас есть конкретные вопросы относительно результатов анализа на стрептококк группы B, рекомендуется обсудить их с вашим врачом. Врач сможет предоставить детальную информацию и необходимые рекомендации на основе конкретных обстоятельств вашего случая.
Запишитесь на консультацию к специалисту
ЗаписатьсяПоложительный анализ на стрептококк группы B
Положительный результат анализа на стрептококк группы B (Streptococcus agalactiae) означает, что бактерия была обнаружена в образце, взятом из области влагалища или ректума. Присутствие стрептококка группы B у беременных женщин может иметь различные причины:
- Носительство:
Большинство случаев положительных результатов связано с тем, что женщина является носителем стрептококка группы B. Носительство означает, что бактерия находится в организме, но не обязательно вызывает заболевание или симптомы. - Периодическое носительство:
Носительство стрептококка группы B может быть периодическим и изменяться в разные периоды времени. Иногда женщины, которые ранее были негативными, могут стать положительными, и наоборот. - Случайные колебания:
Результаты анализа могут подвергаться случайным колебаниям, и положительный результат может быть связан с временным присутствием бактерии в образце.
Важно отметить, что положительный анализ на стрептококк группы B не обязательно означает наличие активной инфекции. Многие женщины, которые являются носителями, остаются асимптоматичными. Тем не менее, в случае беременности положительный результат может потребовать принятия мер по предотвращению передачи бактерии новорожденному, например, приема антибиотиков во время родов.
Если у вас есть вопросы или беспокойства относительно положительного результата анализа на стрептококк группы B, рекомендуется обсудить их с врачом. Врач сможет предоставить дополнительную информацию и, при необходимости, разъяснить дальнейшие шаги и лечение.
Подготовка к анализу на стрептококк группы B
Анализ на стрептококк группы B (Streptococcus agalactiae) обычно не требует особой подготовки, но важно следовать инструкциям вашего врача. Вот общие рекомендации для подготовки к анализу:
- Обсудите с врачом:
Перед проведением анализа обсудите с вашим врачом необходимость и цель этого теста. Врач может дать дополнительные рекомендации, основанные на вашей медицинской истории и беременности. - Возможные ограничения приема антибиотиков:
Если вы принимали антибиотики в ближайшее время до анализа, уведомите врача. В некоторых случаях, прием антибиотиков может повлиять на результаты теста. - Требования по времени проведения теста:
Врач может рекомендовать проведение теста на стрептококк группы B в определенное время беременности, обычно между 35 и 37 неделями. Соблюдение этого временного интервала обеспечивает оптимальную информацию для предотвращения передачи бактерии новорожденному. - Необходимость взятия мазка:
Тест на стрептококк группы B обычно включает в себя взятие мазка из области влагалища и/или прямого культурального анализа. Процедура может вызвать некоторый дискомфорт, но обычно является безопасной и быстрой. - Соблюдение гигиенических правил:
Перед проведением теста следует соблюдать гигиенические правила. Тщательно вымойте руки перед процедурой. - Следуйте рекомендациям врача:
Важно следовать конкретным рекомендациям вашего врача. Если у вас есть какие-либо вопросы относительно подготовки к анализу, не стесняйтесь задавать их врачу.
Помните, что правила подготовки могут немного различаться в зависимости от медицинской практики и страны. Поэтому важно детально обсудить с врачом все аспекты анализа и его подготовки в вашем конкретном случае.